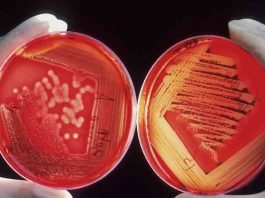
Ο λόγος που ο Candida Auris τρομάζει πολύ περισσότερο απ’ τον κορωνοϊό

Ναυάγιο της Πύλου: Πώς δούλεψε το πραγματικό κύκλωμα διακίνησης- SOLOMON
Aγαπητή αναγνώστρια / αγαπητέ αναγνώστη,
Πριν από λίγες ημέρες μοιραστήκαμε τη νέα έρευνα που δημοσιεύσαμε για την υπόθεση της Πύλου.
Στην έρευνα αυτή, για την οποία δουλέψαμε...
Παραιτήθηκε από υφυπουργός Εθνικής Άμυνας ο Ν. Χαρδαλιάς
Η παραίτηση του Νίκου Χαρδαλιά επιτέλους ήρθε, με μεγάλη καθυστέρηση, αναφέρει σε ανάρτηση του ο Γιάννης Σγουρός
Παραιτήθηκε από υφυπουργός Εθνικής Άμυνας ο Νίκος Χαρδαλιάς,...
Συζήτηση: “Η πανδημία, οι επιπτώσεις της και η ανάγκη για μια ελπιδοφόρα απάντηση της...
Την Κυριακή 17 Ιανουαρίου, στις 7 μμ, το Σύγχρονο Κομμουνιστικό Σχέδιο διοργανώνει ενδιαφέρουσα διαδικτυακή εκδήλωση με κέντρο προβληματισμού τις πολιτικές, οικονομικές και υγειονομικές εξελίξεις που αλληλοτροφοδοτούνται από...
Φωτιά στη Βορειοανατολική Αττική: Εικόνες βιβλικής καταστροφής – Πύρινος ανεμοστρόβιλος στο γήπεδο του Διονύσου
Εφιαλτικές διαστάσεις έχει λάβει η φωτιά που καίει ανεξέλεγκτα στη Βορειοανατολική Αττική εδώ και 13 ώρες.
Συγκλονίζουν τα βίντεο που έρχονται στο φως της δημοσιότητας και δείχνουν...
Ισλανδία: Τεράστια επιτυχία η πολιτική εφαρμογή τετραήμερης εργασίας
Οι δοκιμές για τέσσερις ημέρες εργασίας την εβδομάδα χαρακτηρίστηκαν από απόλυτη επιτυχία και πολλοί εργαζόμενοι αποφάσισαν να μειώσουν τις ώρες εργασίας τους, αναφέρει μελέτη...
Κλιμακώνουν τις κινητοποιήσεις τους οι εργαζόμενοι στους Δήμους
Το ερχόμενο Σάββατο, 2 Μαρτίου 2024, πραγματοποιείται στην Αθήνα, στο Ξενοδοχείο «CARAVEL», η ΙΖ΄ Γενική Συνέλευση της Κεντρικής Ένωσης Δήμων Ελλάδας (ΚΕΔΕ).
Σύμφωνα με ενημέρωση της Π.Ο.Ε.-Ο.Τ.Α, οι εργαζόμενοι...
Θα μοιραστούν δώρα…
Και στο τέλος θα μοιραστούν δώρα
σ όσους μείνουν παντρεμένοι!!!
Επίδομα ρεύματος «Power Pass»: Ανακοινώθηκε ημερομηνία πληρωμής – Πότε θα λάβουν χρήματα οι δικαιούχοι
Για δύο εβδομάδες θα είναι ανοιχτή η πλατφόρμα για να κάνουν αίτηση οι δικαιούχοι του Power Pass, σύμφωνα με νέες δηλώσεις του αναπληρωτή υπουργού...
Πολυτεχνείο: Ξεκινούν την Παρασκευή 15/11 οι εκδηλώσεις για την εξέγερση του Πολυτεχνείου
Πάνω από 5.000 αστυνομικοί για την Πορεία στην αμερικανική πρεσβεία
Αρχίζουν την Παρασκευή 15 Νοεμβρίου οι τριήμερες εκδηλώσεις για την εξέγερση του Πολυτεχνείου και θα κορυφωθούν την Κυριακή 17...